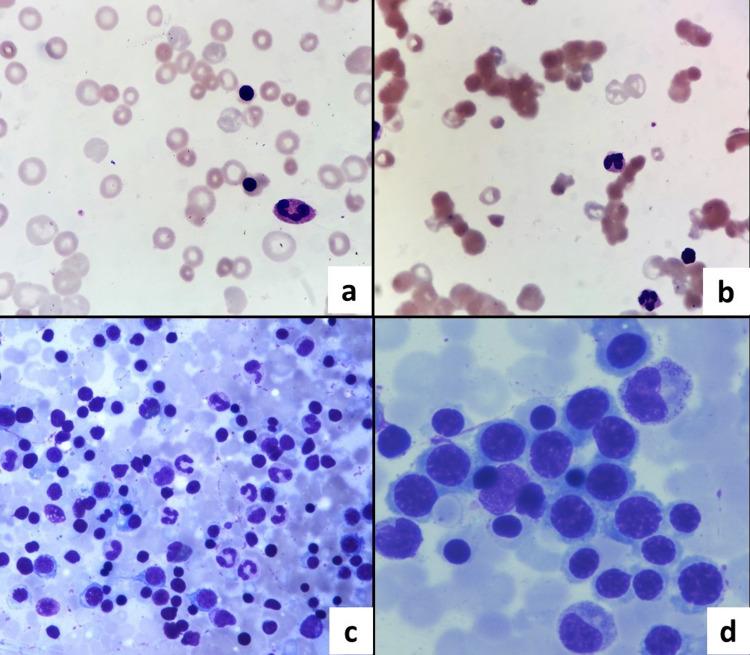
https://cdn.ncbi.nlm.nih.gov/pmc/blobs/4268/8179951/63fbf322657a/cureus-0013-00000014880-i01.jpg

以免疫性溶血性贫血为表现的慢性肝病:资源有限的医疗环境中危重症患者的诊断挑战
Chronic Liver Disease Presenting as Immune Hemolytic Anemia: The Challenges of Diagnosis in the Critically Ill in a Resource-Limited Health Care Setting.
作者信息
Gaur Kavita, Puri Vandana, Agarwal Kiran, Suman Santosh, Dhamija Rajinder K
机构信息
Department of Pathology, Lady Hardinge Medical College, Delhi, IND.
Department of Medicine, Lady Hardinge Medical College, Delhi, IND.
出版信息
Cureus. 2021 May 6;13(5):e14880. doi: 10.7759/cureus.14880.
Immune hemolytic anemia is very rarely associated with chronic liver disease. Diagnosis is often complicated in critically ill patients, where an etiological diagnosis can be elusive, especially in routine health care settings. A 48-year-old man presented with jaundice for three months. Ultrasonography showed features of chronic liver disease. Fibroscan showed increased parenchymal stiffness suggesting cirrhosis. Investigations revealed immune hemolytic anemia and thrombocytopenia. A percutaneous liver biopsy was not performed due to worsening thrombocytopenia. Isolated protein C deficiency and portal vein thrombosis were noted in subsequent testing. The patient eventually succumbed to illness. Coagulopathy such as protein C and D-dimer elevation discovered in subsequent rounds of testing may be misleading in rapidly deteriorating patients, emphasizing the need for timely coagulation workup and imaging. Despite comprehensive testing, lack of liver biopsy, as seen herein, may hamper clinical management. Training residents in the skill of transjugular liver biopsy is necessary to manage critical patients at secondary health care facilities.
免疫性溶血性贫血与慢性肝病的关联极为罕见。在危重症患者中,诊断往往很复杂,病因诊断可能难以明确,尤其是在常规医疗环境中。一名48岁男性出现黄疸三个月。超声检查显示有慢性肝病特征。肝脏硬度值测定显示实质硬度增加提示肝硬化。检查发现免疫性溶血性贫血和血小板减少。由于血小板减少恶化,未进行经皮肝活检。后续检测发现孤立性蛋白C缺乏和门静脉血栓形成。患者最终因病死亡。在后续检测中发现的诸如蛋白C和D - 二聚体升高之类的凝血病,在病情迅速恶化的患者中可能会产生误导,这强调了及时进行凝血检查和影像学检查的必要性。尽管进行了全面检测,但如本文所述,缺乏肝活检可能会妨碍临床管理。在二级医疗机构培训住院医师经颈静脉肝活检技能对于管理危重症患者很有必要。